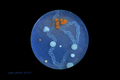
planet x

sve i svašta može biti motiv :-)

visoki napon
31. 03. 2008.
prostori
viđena: 2721 puta
broj komentara: 4
|

kanona
06. 04. 2008.
eksterijeri
viđena: 2332 puta
broj komentara: 5
|

slijedi svoj s…
05. 06. 2008.
i čovjek
viđena: 2441 puta
broj komentara: 23
|

gospodar vreme…
11. 06. 2008.
ulica
viđena: 2530 puta
broj komentara: 2
|

tires in the s…
05. 07. 2008.
apstrakcije
viđena: 4649 puta
broj komentara: 11
|

stara hiža
31. 08. 2008.
detalji
viđena: 2531 puta
broj komentara: 14
|

mikado
22. 09. 2008.
ostalo/razno
viđena: 2332 puta
broj komentara: 4
|

spirala svjetla
07. 10. 2008.
detalji
viđena: 2362 puta
broj komentara: 11
|

nasukani
30. 10. 2008.
mrtva priroda
viđena: 2321 puta
broj komentara: 13
|

Alan's Ps…
07. 11. 2008.
eksperimenti
viđena: 2259 puta
broj komentara: 20
|

|

zbogom blagdani
09. 01. 2009.
prostori
viđena: 2379 puta
broj komentara: 11
|

fotolet
15. 01. 2009.
fotografi
viđena: 2444 puta
broj komentara: 25
|

wish you were …
10. 02. 2009.
apstrakcije
viđena: 2550 puta
broj komentara: 27
|

poslije mise
16. 02. 2009.
i čovjek
viđena: 2289 puta
broj komentara: 9
|

speak to me
25. 02. 2009.
mrtva priroda
viđena: 2056 puta
broj komentara: 20
|

napuštena
02. 03. 2009.
mrtva priroda
viđena: 2169 puta
broj komentara: 18
|

marin držić
11. 03. 2009.
detalji
viđena: 2155 puta
broj komentara: 2
|

u vrtu nasukana
22. 03. 2009.
mrtva priroda
viđena: 2094 puta
broj komentara: 8
|

|

the hall of co…
12. 04. 2009.
prostori
viđena: 1943 puta
broj komentara: 3
|

nasukani
09. 05. 2009.
mrtva priroda
viđena: 2062 puta
broj komentara: 9
|

ispred sv. mar…
02. 06. 2009.
i čovjek
viđena: 2157 puta
broj komentara: 4
|

hod po krijesn…
20. 06. 2009.
igra
viđena: 1938 puta
broj komentara: 11
|

skok
12. 07. 2009.
sport
viđena: 2137 puta
broj komentara: 44
|

kraljević
27. 07. 2009.
i čovjek
viđena: 1871 puta
broj komentara: 12
|

dobro jutro ca…
29. 08. 2009.
panorame
viđena: 1922 puta
broj komentara: 15
|

znatiželja
13. 09. 2009.
ulica
viđena: 1857 puta
broj komentara: 11
|

svjetlo na kra…
21. 09. 2009.
prostori
viđena: 2006 puta
broj komentara: 24
|

night cycling
22. 09. 2009.
ulica
viđena: 1865 puta
broj komentara: 13
|

rolling in the…
23. 09. 2009.
putopisi
viđena: 1840 puta
broj komentara: 14
|

osječki za noć…
24. 09. 2009.
u pejzažu
viđena: 1971 puta
broj komentara: 21
|

fiš
25. 09. 2009.
hrana
viđena: 1913 puta
broj komentara: 8
|

butelje
26. 09. 2009.
interijeri
viđena: 2017 puta
broj komentara: 31
|

osijek, trg sv…
26. 09. 2009.
panorame
viđena: 1864 puta
broj komentara: 5
|

pozdrav iz lip…
07. 10. 2009.
putopisi
viđena: 1688 puta
broj komentara: 12
|

sjene jutra
04. 11. 2009.
ostalo/razno
viđena: 1763 puta
broj komentara: 8
|

život na površ…
19. 11. 2009.
apstrakcije
viđena: 2090 puta
broj komentara: 12
|

planet pile
10. 12. 2009.
eksperimenti
viđena: 3989 puta
broj komentara: 22
|

me, myself and…
17. 12. 2009.
i čovjek
viđena: 2160 puta
broj komentara: 11
|

čestitka
22. 12. 2009.
ostalo/razno
viđena: 1837 puta
broj komentara: 30
|

speak to me (2)
02. 01. 2010.
mrtva priroda
viđena: 1938 puta
broj komentara: 15
|

44
18. 01. 2010.
putovanja
viđena: 1937 puta
broj komentara: 27
|

nso
21. 01. 2010.
sport
viđena: 1880 puta
broj komentara: 13
|

libertas
12. 03. 2010.
i čovjek
viđena: 2025 puta
broj komentara: 22
|

u akvariju
13. 03. 2010.
prostori
viđena: 1706 puta
broj komentara: 25
|

posljednja utr…
16. 03. 2010.
predmeti: vozila
viđena: 1721 puta
broj komentara: 11
|

planet zine
24. 03. 2010.
fotografi
viđena: 1822 puta
broj komentara: 24
|

biogradski mot…
27. 03. 2010.
detalji
viđena: 1641 puta
broj komentara: 27
|

skradin
03. 04. 2010.
panorame
viđena: 1787 puta
broj komentara: 22
|

primirje
23. 04. 2010.
mrtva priroda
viđena: 1719 puta
broj komentara: 9
|

na ispaši
01. 05. 2010.
životinje
viđena: 1564 puta
broj komentara: 11
|

din don
02. 05. 2010.
interijeri
viđena: 1578 puta
broj komentara: 7
|

susret u tvrđi
16. 06. 2010.
ulica
viđena: 1571 puta
broj komentara: 26
|

koliko kapi to…
18. 06. 2010.
mrtva priroda
viđena: 2366 puta
broj komentara: 9
|

moja mama na s…
27. 06. 2010.
i čovjek
viđena: 1598 puta
broj komentara: 11
|

pogled prema n…
28. 06. 2010.
u pejzažu
viđena: 1543 puta
broj komentara: 12
|

u bastionu
17. 07. 2010.
interijeri
viđena: 1691 puta
broj komentara: 23
|

silazak
25. 07. 2010.
prostori
viđena: 1722 puta
broj komentara: 22
|

vruće vijesti
22. 08. 2010.
ostalo/razno
viđena: 1368 puta
broj komentara: 14
|

radost tuširan…
08. 09. 2010.
fotografi
viđena: 1533 puta
broj komentara: 11
|

color shopping
10. 09. 2010.
interijeri
viđena: 1645 puta
broj komentara: 27
|

|

hotel termag
04. 01. 2011.
eksterijeri
viđena: 1608 puta
broj komentara: 9
|

hotel termag 2
06. 01. 2011.
u pejzažu
viđena: 1474 puta
broj komentara: 13
|

borderica
08. 01. 2011.
sport
viđena: 1645 puta
broj komentara: 8
|

tumarajući snj…
09. 01. 2011.
putovanja
viđena: 1580 puta
broj komentara: 20
|

bačvasta disto…
18. 01. 2011.
putovanja
viđena: 1815 puta
broj komentara: 18
|

45
19. 01. 2011.
putovanja
viđena: 2345 puta
broj komentara: 73
|

dodir vjere
05. 02. 2011.
dokumentarna
viđena: 1520 puta
broj komentara: 14
|

na gorici
09. 02. 2011.
dokumentarna
viđena: 1634 puta
broj komentara: 9
|

u procesiji
11. 02. 2011.
ulica
viđena: 1384 puta
broj komentara: 7
|

svježe pituran…
30. 04. 2011.
ostalo/razno
viđena: 1589 puta
broj komentara: 4
|

In memoriam To…
02. 06. 2011.
ostalo/razno
viđena: 1500 puta
broj komentara: 4
|

branica
27. 06. 2011.
ostalo/razno
viđena: 1344 puta
broj komentara: 4
|

vatroslav
09. 07. 2011.
ostalo/razno
viđena: 1374 puta
broj komentara: 15
|

vatrena plesač…
11. 07. 2011.
ostalo/razno
viđena: 1402 puta
broj komentara: 9
|

projekcija
28. 09. 2011.
dokumentarna
viđena: 1493 puta
broj komentara: 15
|

kućica
06. 10. 2011.
detalji
viđena: 1355 puta
broj komentara: 16
|

ožujska
08. 10. 2011.
putopisi
viđena: 1300 puta
broj komentara: 11
|

fly me to the …
20. 10. 2011.
ostalo/razno
viđena: 1284 puta
broj komentara: 5
|

sretna obitelj
11. 11. 2011.
ostalo/razno
viđena: 1332 puta
broj komentara: 20
|

šeširi
11. 12. 2011.
mrtva priroda
viđena: 1569 puta
broj komentara: 20
|

stonske zidine
19. 12. 2011.
u pejzažu
viđena: 1405 puta
broj komentara: 13
|

gospa od puta
18. 01. 2012.
ostalo/razno
viđena: 1239 puta
broj komentara: 23
|

fasadex
25. 01. 2012.
detalji
viđena: 1460 puta
broj komentara: 16
|

defragmentacija
28. 03. 2012.
prostori
viđena: 1574 puta
broj komentara: 22
|

glasses
12. 05. 2012.
ostalo/razno
viđena: 1356 puta
broj komentara: 8
|

akvarel
13. 05. 2012.
ulica
viđena: 1246 puta
broj komentara: 9
|

|

|

|

vozni park 1
16. 05. 2012.
ostalo/razno
viđena: 1376 puta
broj komentara: 9
|

jana
17. 05. 2012.
ostalo/razno
viđena: 1312 puta
broj komentara: 8
|

|

konavoski bager
23. 05. 2012.
predmeti: vozila
viđena: 1264 puta
broj komentara: 4
|

ludo kamenje
26. 06. 2012.
mrtva priroda
viđena: 1272 puta
broj komentara: 4
|

pripremanje ob…
11. 09. 2012.
ulica
viđena: 1174 puta
broj komentara: 10
|

glave
13. 09. 2012.
mrtva priroda
viđena: 1428 puta
broj komentara: 17
|

odličja
19. 09. 2012.
ostalo/razno
viđena: 1261 puta
broj komentara: 5
|

male ruke
25. 09. 2012.
ostalo/razno
viđena: 1188 puta
broj komentara: 4
|

|

let iznad čili…
16. 10. 2012.
ostalo/razno
viđena: 1281 puta
broj komentara: 14
|

nar
29. 10. 2012.
makro
viđena: 1373 puta
broj komentara: 15
|

phobia 2
30. 11. 2012.
apstrakcije
viđena: 1367 puta
broj komentara: 9
|

viper i joulup…
24. 12. 2012.
igra
viđena: 1426 puta
broj komentara: 20
|

novogodišnja č…
31. 12. 2012.
ostalo/razno
viđena: 1301 puta
broj komentara: 13
|

30
13. 01. 2013.
ostalo/razno
viđena: 1076 puta
broj komentara: 7
|

komplementi 1/4
15. 01. 2013.
predmeti: vozila
viđena: 1184 puta
broj komentara: 16
|

komplementi 2/4
15. 01. 2013.
predmeti: vozila
viđena: 1336 puta
broj komentara: 22
|

komplementi 3/4
15. 01. 2013.
predmeti: vozila
viđena: 1321 puta
broj komentara: 18
|

komplementi 4/4
16. 01. 2013.
predmeti: vozila
viđena: 1217 puta
broj komentara: 14
|

brončani dubro…
26. 01. 2013.
ostalo/razno
viđena: 1209 puta
broj komentara: 10
|

maro i baro
27. 01. 2013.
ostalo/razno
viđena: 1064 puta
broj komentara: 2
|

zaključani dof
15. 03. 2013.
mrtva priroda
viđena: 1275 puta
broj komentara: 11
|

falsi potok
17. 03. 2013.
ostalo/razno
viđena: 1061 puta
broj komentara: 11
|

falsi potok 2
17. 03. 2013.
voda
viđena: 1130 puta
broj komentara: 9
|

u korti nasuka…
23. 03. 2013.
predmeti: vozila
viđena: 1232 puta
broj komentara: 11
|

Sretan Uskrs :)
30. 03. 2013.
mrtva priroda
viđena: 1157 puta
broj komentara: 11
|

uskrsna noć
01. 04. 2013.
pejzaži
viđena: 1135 puta
broj komentara: 8
|

pliska
02. 04. 2013.
eksperimenti
viđena: 1201 puta
broj komentara: 14
|

pliska 2
02. 04. 2013.
eksperimenti
viđena: 1159 puta
broj komentara: 12
|

|

legionar
24. 04. 2013.
kamen
viđena: 1361 puta
broj komentara: 9
|

orebić
04. 05. 2013.
panorame
viđena: 1182 puta
broj komentara: 5
|

duba
05. 05. 2013.
u pejzažu
viđena: 1107 puta
broj komentara: 6
|

planet x
14. 05. 2013.
makro
viđena: 1282 puta
broj komentara: 13
|

u samostanu
17. 05. 2013.
interijeri
viđena: 1200 puta
broj komentara: 4
|

ono nešto
28. 05. 2013.
apstrakcije
viđena: 1257 puta
broj komentara: 6
|

čudna neka voz…
04. 07. 2013.
mrtva priroda
viđena: 1264 puta
broj komentara: 8
|

palma
11. 07. 2013.
ostalo/razno
viđena: 1226 puta
broj komentara: 38
|

crescendo
11. 07. 2013.
ostalo/razno
viđena: 1088 puta
broj komentara: 14
|

prelet preko b…
21. 07. 2013.
putovanja
viđena: 1354 puta
broj komentara: 15
|

mrki međed
21. 08. 2013.
makro
viđena: 1159 puta
broj komentara: 7
|

igre na gradcu
29. 08. 2013.
dokumentarna
viđena: 1076 puta
broj komentara: 5
|

porporelaši
15. 10. 2013.
ostalo/razno
viđena: 1084 puta
broj komentara: 8
|

pilarice
16. 10. 2013.
ostalo/razno
viđena: 1020 puta
broj komentara: 9
|

na marinu
10. 11. 2013.
ostalo/razno
viđena: 1074 puta
broj komentara: 10
|

izložba
11. 11. 2013.
dokumentarna
viđena: 1083 puta
broj komentara: 9
|

(foto. br. 603074)
26. 11. 2013.
predmeti: vozila
viđena: 1119 puta
broj komentara: 6
|

arafilija
01. 12. 2013.
dokumentarna
viđena: 1152 puta
broj komentara: 7
|

čestitka
24. 12. 2013.
ostalo/razno
viđena: 1142 puta
broj komentara: 10
|

čudno drvo
04. 01. 2014.
mrtva priroda
viđena: 1353 puta
broj komentara: 6
|

betlehem
05. 01. 2014.
ostalo/razno
viđena: 1108 puta
broj komentara: 7
|

betlehem 2
06. 01. 2014.
ostalo/razno
viđena: 1029 puta
broj komentara: 5
|

6.1.2014.
06. 01. 2014.
ostalo/razno
viđena: 1071 puta
broj komentara: 11
|

život u kocki
07. 01. 2014.
i čovjek
viđena: 1203 puta
broj komentara: 14
|

foot fetish wi…
22. 01. 2014.
detalji
viđena: 1311 puta
broj komentara: 16
|

man in black
04. 02. 2014.
ulica
viđena: 1275 puta
broj komentara: 23
|

mickey
05. 02. 2014.
ulica
viđena: 1196 puta
broj komentara: 15
|

žuta petokraka
06. 02. 2014.
ostalo/razno
viđena: 1064 puta
broj komentara: 9
|

hitna
07. 02. 2014.
ulica
viđena: 1103 puta
broj komentara: 14
|

dud art 2014
08. 02. 2014.
biljke
viđena: 1172 puta
broj komentara: 20
|

klik-klak
11. 02. 2014.
eksperimenti
viđena: 1297 puta
broj komentara: 8
|

locked ;)
24. 02. 2014.
ostalo/razno
viđena: 1223 puta
broj komentara: 6
|

fasada
28. 02. 2014.
detalji
viđena: 1249 puta
broj komentara: 18
|

slobodan udarac
18. 03. 2014.
sport
viđena: 1170 puta
broj komentara: 17
|

kajakaš
15. 04. 2014.
sport
viđena: 1180 puta
broj komentara: 1
|

neumorna posti…
17. 04. 2014.
dokumentarna
viđena: 1022 puta
broj komentara: 7
|

sretan uskrs
18. 04. 2014.
mrtva priroda
viđena: 1418 puta
broj komentara: 17
|

|

kruh snimatelj…
27. 04. 2014.
hrana
viđena: 1218 puta
broj komentara: 10
|

dubrovačka pol…
08. 05. 2014.
predmeti: vozila
viđena: 1057 puta
broj komentara: 6
|

|

yogomania 2
24. 05. 2014.
hrana
viđena: 1209 puta
broj komentara: 15
|

yogomania 3
24. 05. 2014.
interijeri
viđena: 1233 puta
broj komentara: 20
|

servis
26. 05. 2014.
sport
viđena: 1312 puta
broj komentara: 6
|

spašavanje žut…
26. 05. 2014.
sport
viđena: 1138 puta
broj komentara: 9
|

stijepo ponovo…
28. 05. 2014.
fotografi
viđena: 1335 puta
broj komentara: 12
|

kvadratura kru…
31. 05. 2014.
eksterijeri
viđena: 1005 puta
broj komentara: 9
|

web
21. 06. 2014.
mrtva priroda
viđena: 1471 puta
broj komentara: 25
|

hand made - in…
15. 08. 2014.
mrtva priroda
viđena: 1230 puta
broj komentara: 7
|

začuđeni
17. 08. 2014.
koncerti
viđena: 1159 puta
broj komentara: 12
|

colonia
18. 08. 2014.
koncerti
viđena: 1307 puta
broj komentara: 7
|

sanjina kuhinja
06. 09. 2014.
interijeri
viđena: 1502 puta
broj komentara: 23
|

spavaća soba
14. 09. 2014.
interijeri
viđena: 1211 puta
broj komentara: 8
|

interijer
14. 09. 2014.
interijeri
viđena: 1401 puta
broj komentara: 11
|

iva vozi na st…
17. 10. 2014.
predmeti: vozila
viđena: 1297 puta
broj komentara: 5
|

netko je duhov…
24. 10. 2014.
mrtva priroda
viđena: 1348 puta
broj komentara: 10
|

mali krumpiri
29. 10. 2014.
ostalo/razno
viđena: 1215 puta
broj komentara: 12
|

trgovina
30. 10. 2014.
ulica
viđena: 876 puta
broj komentara: 3
|

dodir
30. 10. 2014.
posao
viđena: 1026 puta
broj komentara: 6
|

mali krumpiri 2
31. 10. 2014.
ulica
viđena: 925 puta
broj komentara: 8
|

zlatna konstru…
01. 11. 2014.
detalji
viđena: 1010 puta
broj komentara: 9
|

uredna tiramola
26. 11. 2014.
ostalo/razno
viđena: 976 puta
broj komentara: 22
|

dubrovački rad…
28. 11. 2014.
dokumentarna
viđena: 991 puta
broj komentara: 7
|

navala na kupus
30. 11. 2014.
ostalo/razno
viđena: 889 puta
broj komentara: 6
|

zvonik
20. 02. 2015.
apstrakcije
viđena: 1107 puta
broj komentara: 2
|

kao picasso
22. 02. 2015.
apstrakcije
viđena: 1085 puta
broj komentara: 15
|

kao gaudi
22. 02. 2015.
apstrakcije
viđena: 1172 puta
broj komentara: 16
|

|

|

Lucija
28. 02. 2015.
ostalo/razno
viđena: 834 puta
broj komentara: 4
|

(foto. br. 654259)
12. 03. 2015.
ostalo/razno
viđena: 934 puta
broj komentara: 7
|

(foto. br. 654786)
19. 03. 2015.
i čovjek
viđena: 1066 puta
broj komentara: 10
|

tonći u prolaz…
21. 03. 2015.
ulica
viđena: 966 puta
broj komentara: 9
|

sretan uskrs
04. 04. 2015.
ostalo/razno
viđena: 1102 puta
broj komentara: 15
|

cipelice plave
03. 05. 2015.
ulica
viđena: 1223 puta
broj komentara: 16
|

prema bakuu
05. 05. 2015.
sport
viđena: 1290 puta
broj komentara: 4
|

pogled
11. 06. 2015.
cvijeće
viđena: 1075 puta
broj komentara: 8
|

|

lokrumski zidi
29. 07. 2015.
detalji
viđena: 1182 puta
broj komentara: 11
|

srdele
08. 08. 2015.
hrana
viđena: 1151 puta
broj komentara: 6
|

ime ruže
20. 08. 2015.
cvijeće
viđena: 1132 puta
broj komentara: 5
|

u autobusu
21. 08. 2015.
putovanja
viđena: 1329 puta
broj komentara: 14
|

geolight
23. 08. 2015.
detalji
viđena: 1267 puta
broj komentara: 6
|

|

|

bioraznolikost…
20. 10. 2015.
dokumentarna
viđena: 1368 puta
broj komentara: 22
|

prstenovanje
25. 10. 2015.
dokumentarna
viđena: 1003 puta
broj komentara: 8
|

sretni blagdani
23. 12. 2015.
ostalo/razno
viđena: 840 puta
broj komentara: 4
|

sretan božić
24. 12. 2015.
ostalo/razno
viđena: 903 puta
broj komentara: 5
|

sretna vam nov…
30. 12. 2015.
ostalo/razno
viđena: 1004 puta
broj komentara: 9
|

pozdrav iz kol…
08. 02. 2016.
ulica
viđena: 946 puta
broj komentara: 16
|

trombunjeri
09. 02. 2016.
apstrakcije
viđena: 1161 puta
broj komentara: 21
|

ombrela i mitre
09. 02. 2016.
ulica
viđena: 1037 puta
broj komentara: 3
|

ruke barjaktara
10. 02. 2016.
ostalo/razno
viđena: 1071 puta
broj komentara: 7
|

nabadanje
16. 02. 2016.
ulica
viđena: 1114 puta
broj komentara: 4
|

(foto. br. 678258)
14. 03. 2016.
ostalo/razno
viđena: 984 puta
broj komentara: 7
|

vesela jajca
26. 03. 2016.
ostalo/razno
viđena: 940 puta
broj komentara: 16
|

moja nova igra…
08. 04. 2016.
mrtva priroda
viđena: 1706 puta
broj komentara: 34
|

plastične žene…
13. 04. 2016.
ostalo/razno
viđena: 935 puta
broj komentara: 7
|

stampedo
02. 05. 2016.
sport
viđena: 1324 puta
broj komentara: 4
|

osvježenje
02. 05. 2016.
ostalo/razno
viđena: 997 puta
broj komentara: 11
|

house
08. 05. 2016.
interijeri
viđena: 1274 puta
broj komentara: 10
|

|

oprezno u prom…
26. 05. 2016.
dokumentarna
viđena: 1089 puta
broj komentara: 10
|

alien
03. 07. 2016.
apstrakcije
viđena: 1405 puta
broj komentara: 24
|

IR pogled kroz…
16. 07. 2016.
eksperimenti
viđena: 1165 puta
broj komentara: 7
|

bee free
16. 07. 2016.
eksperimenti
viđena: 1160 puta
broj komentara: 10
|

noemi
23. 07. 2016.
dokumentarna
viđena: 1187 puta
broj komentara: 12
|

|

|

ribolovke
14. 09. 2016.
ostalo/razno
viđena: 886 puta
broj komentara: 8
|

|

...pojma nemaju
04. 10. 2016.
ostalo/razno
viđena: 992 puta
broj komentara: 4
|

|